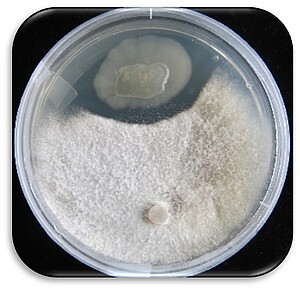

Topic ID No.: 2026-G01
Title of research topic:
Discovery and Evaluation of Novel Lipopeptides for Agricultural Fungal Disease Management
Description:
Lipopeptides, microbially produced amphiphilic compounds, usually exhibit bioactivity, particularly against agricultural fungal diseases. These biomolecules are considered to be biodegradable and generally environmentally friendly. Unlike synthetic fungicides, these compounds display a wide range of unique structures and physico-chemical properties, the general understanding is that there is an application for biocontrol in many different crops.
This proposed project aims to evaluate the use of lipopeptides and other bacterially produced bioactives to combat crop fungal diseases, a significant threat to agricultural production worldwide.
This PhD project combines the searching for novel lipopeptides from metagenomic sources at IMBM at UWC (Cape Town, South Africa) with genetic engineering and expression in recombinant hosts, their bioproduction, as well as characterization and potential applications against fungi diseases.
Target region or country (if applicable):
South Africa
Topic background information / scientific relevance:
Fungal diseases represent a major threat to global food security, causing substantial crop losses and economic damage every year. Conventional fungicides, though effective, often raise environmental and health concerns due to their persistence, toxicity, and the emergence of resistant pathogen strains. In this context, microbial secondary metabolites - particularly lipopeptides - offer a sustainable and versatile alternative. Lipopeptides are amphiphilic biomolecules produced mainly by Bacillus and Pseudomonas species, exhibiting potent antifungal, antibacterial, and surfactant properties. Their biodegradability, low toxicity, and structural diversity make them highly attractive for application in biocontrol and plant protection.
Recent advances in genomics and metagenomics have revealed an enormous untapped potential for novel bioactive compounds encoded within microbial communities. However, many of these biosynthetic gene clusters remain silent under standard cultivation conditions and require heterologous expression systems and genetic engineering to unlock their production.
This project addresses this research gap by integrating metagenomic discovery of novel lipopeptides and bioactive compounds at IMBM (UWC, South Africa) with synthetic biology and bioprocess engineering approaches for their production and functional evaluation. By coupling modern omics-based discovery with recombinant expression and bioassay-guided screening, the project aims to identify and characterize new molecules effective against fungal phytopathogens. The outcomes will contribute to developing eco-friendly crop protection strategies, advancing scientific understanding of microbial bioactive diversity, and strengthening international collaboration in sustainable agricultural biotechnology.
Research objectives:
This project aims to discover, produce, and evaluate novel microbial lipopeptides with antifungal potential for agricultural applications. The specific objectives are: (i) identify and characterize biosynthetic gene clusters from metagenomic libraries at IMBM (UWC); (ii) clone and express selected candidates in suitable recombinant hosts (eg. Bacillus subtilis, Pseudomonas putida); (iii) optimize bioproduction and purification of promising compounds; and (iv) assess their antifungal activity against relevant crop pathogens.
Required skills and qualifications of the applicant:
The ideal candidate should hold a Master’s degree in Microbiology, Biotechnology, Biochemistry, or a related field. A solid background in molecular biology techniques and microbial cultivation is essential. Experience with metagenomics, genetic engineering, or heterologous expression systems will be advantageous. Familiarity with analytical methods such as HPTLC, LC-MS, or bioassays for antimicrobial activity is desirable. The candidate should demonstrate strong problem-solving skills, scientific curiosity, and the ability to work independently and collaboratively in an interdisciplinary and international research environment.
Contact person and institute in charge:
Prof. Dr. Rudolf Hausmann. University of Hohenheim. Head of Department of Bioprocess Engineering.
rudolf.hausmann@uni-hohenheim.de